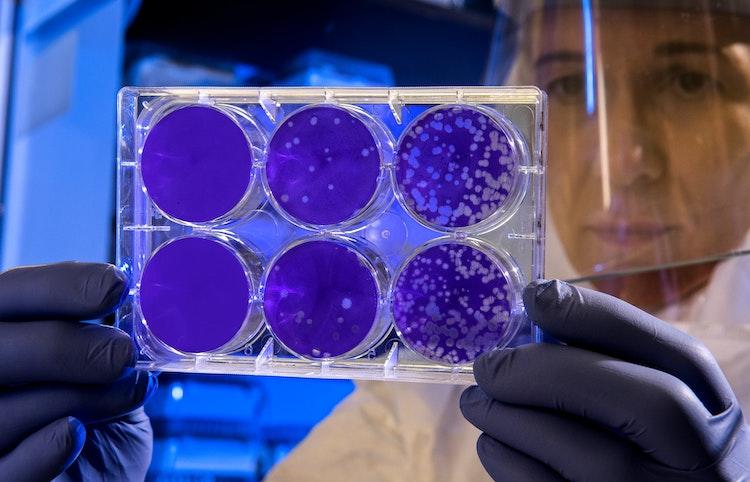
Une scientifique étudie des virus

La biologie est une science majeure, indispensable à la compréhension du monde. Cette science du vivant, étroitement liée à la chimie et à la physique, a pour objet d'étude l'ensemble des êtres vivants, la matière vivante, mais aussi les écosystèmes. Elle englobe bien des domaines d'études et de recherche tels que la biologie cellulaire et moléculaire, la génétique, la biologie médicale, spatiale, la physiologie, mais aussi l'écologie et la biologie de conservation. Depuis des siècles, les Hommes ont avancé grâce aux enseignements tirés de cette science : sans biologie, pas de vaccin, pas de connaissances du génome et de l'hérédité, ou encore des cellules souches. Ainsi, la très grande majorité des avancées médicales ont été faites grâce à la biologie : c'est pourquoi il s'agit d'un domaine si important, qu'il est indispensable de continuer à développer. Charles Darwin, Louis Pasteur, Gregor Mendel, Rachel Carson, Alexander Fleming... autant de grands noms des sciences et de la biologie, qui nous ont permis de mieux comprendre le monde dans lequel nous évoluons.
L'étude de la biologie a débuté réellement à la fin du XVIIIe siècle. Le mot "biologie", formé des mots grecs "bio" (vie) et logos (science, discours), a été utilisé la première fois par l'allemand Theodor Roose et le français Jean-Baptiste de Lamarck aux alentours de 1800. Les découvertes se sont ensuite multipliées au XIXe mais surtout au XXe siècle. Au XXIe siècle, les avancées et percées continuent.
Si vous êtes passionné(e) par ces sujets, et souhaitez les étudier, en faire votre métier, des cours de biologie seront indispensables. Mais il existe d'autres raisons de vouloir progresser en bio : par exemple si vous êtes encore élève en cycle secondaire II et voulez obtenir de meilleurs résultats en sciences.
Dans tous ces cas, nous avons réunis les différents lieux où apprendre la biologie en Suisse romande. Que vous viviez à Lausanne, Genève, Neuchâtel, Sion... voici les meilleures solutions d'apprentissage de la biologie.

Suivre des cours de biologie dans le canton de Vaud
Quels que soient les domaines qui vous passionnent, vous pourrez vous lancer sans difficulté dans cet apprentissage sérieux de la biologie si vous vivez à Lausanne.
L'université de Lausanne
Une fois la maturité obtenue, il est possible de poursuivre des études supérieures à l'université. La capitale du canton de Vaud possède une excellente université, l'UNIL.
Très réputée, elle propose un cursus Bachelor - Master -Doctorat en biologie. Durant les trois premières années, les étudiants acquièrent une image des différents domaines de la biologie, de la molécule aux écosystèmes. Après le Bachelor, un Master, entièrement en anglais, est proposé (avec trois spécialisations différentes).
L'EPFL
L'EPFL est une école d'excellence en Suisse romande. L'Ecole Polytechnique Fédérale de Lausanne possède ainsi un programme de Bachelor en Ingénierie des sciences du vivant. Cette formation se situe au croisement entre les sciences du vivant et les disciplines de l’ingénierie. Les élèves peuvent ensuite poursuivre en Master Ingénierie des sciences du vivant pour compléter leur formation, et devenir ensuite chercheurs et ingénieurs.
Devenir biologiste à Genève
Ville majeure de Suisse romande, Genève dispose de plusieurs solutions d'enseignement de la biologie sur les rives du Léman.
L'université de Genève
L'université de Genève possède un département des sciences. Vous pouvez donc y suivre une formation complète en biologie : Bachelor (3 ans), Master (5 ans), Doctorat (8 ans). Le but du Bachelor est de permettre aux étudiants d’acquérir un éventail de compétences scientifiques fondamentales et professionnelles. Ils y apprennent les connaissances indispensables sur l’origine, la diversité, le développement, la structure et le fonctionnement du vivant. Dès la première année, ils apprennent en outre à manier les techniques utilisées dans la recherche (pour la biologie moléculaire, la génétique, la microbiologie, la physiologie, l'écologie... etc).
Se rendre au Muséum d'Histoire Naturelle
Pourquoi ne pas visiter le Muséum d'Histoire Naturelle de Genève ? Il s'agit d'ailleurs du plus grand de Suisse. Il n'existe pas mieux pour découvrir les espèces animales. Il peut s'agir d'une excellente première sensibilisation aux domaines de la biologie : une bonne idée donc pour les enfants et les jeunes. En complément de ce genre de visites, vous pouvez aussi faire appel à un professeur particulier qui vous dispensera des cours de soutien en biologie.

Progresser en sciences à Fribourg
Vous êtes fribourgeois(e), ou peut-être bullois(e) ? Vous n'aurez aucun mal à trouver votre bonheur pour des leçons de biologie dans le canton bilingue.
Des études à l'université de Fribourg
L'université de Fribourg (UNIFR) propose un cursus complet en biologie, avec d'abord un Bachelor (3 ans), puis un Master (5 ans), et enfin un Doctorat (8 ans).
Durant la première année du Bachelor, les étudiants assimilent les apprentissages de base en sciences : biologie générale, biologie des organismes, mais aussi chimie, mathématiques, physique. Sur les deux années restantes, ils doivent se spécialiser dans le domaine de leur choix, au choix "Biologie des organismes, évolution et écologie" ou "Biologie moléculaire, biochimie, génétique et biologie cellulaire".
Les étudiants de cette formation suivent des cours, travaux pratiques et séminaires, mais sont aussi intégré au sein d'une unité de recherche.
Fidèle au canton de Fribourg qui est bilingue, les cours sont dispensés en deux langues, allemand et français.
Il est ensuite possible d'enchainer sur un Master, voir un Doctorat avec l'écriture d'une thèse.
Apprendre la biologie au sein de la capitale fédérale
Berne, capitale de la Suisse en majorité germanophone, permet aussi à ses habitants de se former en sciences, notamment via son offre universitaire. Voici plusieurs options pour étudier la biologie dans la ville aux ours.
Se former à l'université (UNIBE)
L'université de Berne (en allemand, Universität Bern) dispose d'un département de biologie. Il est composé de trois instituts : biologie cellulaire, botanique, écologie et évolution.
Classiquement, la formation suit le format Bachelor, Master, Doctorat. Les jeunes qui ont obtenu leur maturité débutent ainsi par un Bachelor (3 ans).
Ce Bachelor de biologie de l'UNIBE offre aux futurs biologistes une formation propédeutique solide. L'objectif des deux premières années est de transmettre un large éventail de connaissances en biologie, ainsi que des bases dans les autres sciences naturelles. Les étudiants assistent à des conférences et font des stages, où ils apprennent les méthodes de la recherche biologique.
Les cours sont donnés en allemand et anglais. Ensuite, selon la spécialisation préalablement choisie, les étudiants peuvent poursuivre dans un des masters disponibles.
S'améliorer en biologie sur les rives du lac de Neuchâtel
Neuchâtel, au nord de la Romandie, est un lieu idéal pour se former et devenir biologiste dans ce canton.
L'université de Neuchâtel
À Neuchâtel, vous pouvez faire des études supérieures de qualité en biologie ou biochimie, au sein de l'université de Neuchâtel (UniNE).
Les étudiants y étudient durant leur cursus l'ensemble des niveaux d'organisation du vivant, de la molécule à l'écosystème.
Vous pouvez ainsi débuter par un Bachelor (en trois ans) puis un Master (en cinq ans), en biologie bien sûr, mais aussi en "Biologie et Ethnologie", qui se trouve au croisement entre sciences du vivant et sciences sociales.
Étudier la biologie à Neuchâtel permet de profiter d'un enseignement complet, d'une approche concrète de la biologie grâce aux travaux pratiques, ainsi que d'un environnement international professionnel de chercheurs.
S'éduquer à la bibliothèque
Nous vous conseillons de vous rendre à l'excellente bibliothèque publique et universitaire de Neuchâtel. Ses rayons regorgent d'ouvrages spécialisés et dictionnaires de bio en tout genre. Vous y trouverez tous les manuels nécessaires dans différents domaines de la biologie : biologie générale, biologie végétale, évolutive, moléculaire, biologie marine, biologie de la conservation... et même des livres sur l'histoire de la biologie. Sont également conservés des revues spécialisées, articles, thèses et mémoires, qui sont très utiles si vous avez décidé de creuser un sujet précis.

Suivre des leçons de bio dans le Valais
Sion est le chef-lieu du canton méridional du Valais, au cœur de la vallée du Rhône. La ville ne possède pas d'université à proprement parler, mais des Hautes Écoles et d'autres ressources.
Plusieurs solutions s'offrent à vous pour progresser en biologie dans la cité de Sion.
La Haute École Spécialisée de Suisse Occidentale
La Haute École d'Ingénierie, qui fait partie de la HES-SO, propose une formation d'ingénieur en Technologies du vivant, sous forme de Bachelor et de Master. Technologie alimentaire, biotechnologie, chimie analytique sont les trois composantes de cette formation. Durant le Bachelor, qui vise à former des ingénieurs d'excellence, les étudiants se spécialisent sur une des trois branches. S'ils choisissent la biotechnologie, ils étudieront ainsi différentes facettes de la biologie, via des cours de biologie moléculaire, de génie des bioprocédés, d'immunologie...
Les étudiants peuvent ensuite, s'ils le souhaitent, poursuivre dans le Master in Life Sciences, et choisir la spécialisation en biosciences appliquées.
La médiathèque Valais à Sion
Pour étudier la biologie et tout type de sciences par vous-même, rendez-vous à la Médiathèque Valais, dans le centre-ville de Sion. Elle est accessible à tous. Vous y trouverez des très nombreuses ressources généralistes mais aussi plus spécialisées (livres, manuels, dictionnaires, essais, articles...) pour apprendre la biologie, la biochimie, ou encore la biophysique.
Résumer via IA :










